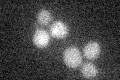
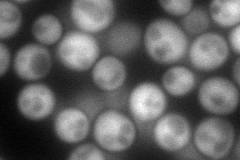

View description
Methionine-R-sulfoxide reductase, reduces the R enantiomer of free Met-SO, in contrast to Ycl033Cp which reduces Met-R-SO in a peptide linkage; has a role in protection against oxidative stress
Localization:
Intensity:
Fold change:
Significance:
-
C’ GFP library in SD
below threshold16.78 -
N' NOP1pr-GFP in SD
cytosol133.957 -
N' TEF2pr-mCherry in SD

cytosol315.144 -
N' NATIVEpr-GFP in SD

missing0 -
N' TEF2pr-VC and Cyto-VN in SD

cytosol71.1875 -
C’ GFP library in SD+DTT

cytosol15.520.92No -
C’ GFP library in SD+H2O2

cytosol16.390.97No -
C’ GFP library in Starvation Media

cytosol18.611.1No -
C’ GFP library on the background of Pup2-DaMP

below threshold -
C’ GFP library on the background of CCT mutant

below threshold16.02630.954638No
